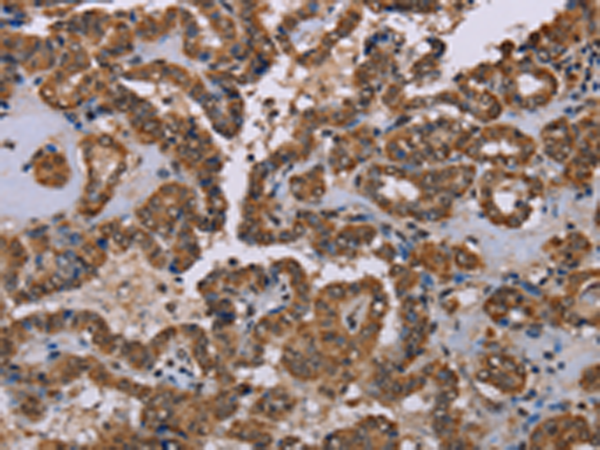
一抗

中文名稱:兔抗GRK1多克隆抗體
|
Background: |
This gene encodes a member of the guanine nucleotide-binding protein (G protein)-coupled receptor kinase subfamily of the Ser/Thr protein kinase family. The protein phosphorylates rhodopsin and initiates its deactivation. Defects in GRK1 are known to cause Oguchi disease 2 (also known as stationary night blindness Oguchi type-2). |
|
Applications: |
ELISA, IHC |
|
Name of antibody: |
GRK1 |
|
Immunogen: |
Synthetic peptide of human GRK1 |
|
Full name: |
G protein-coupled receptor kinase 1 |
|
Synonyms: |
RK; RHOK; GPRK1 |
|
SwissProt: |
Q15835 |
|
ELISA Recommended dilution: |
2000-5000 |
|
IHC positive control: |
Human thyroid cancer and Human esophagus cancer |
|
IHC Recommend dilution: |
50-200 |

 購物車
購物車 幫助
幫助
 021-54845833/15800441009
021-54845833/15800441009